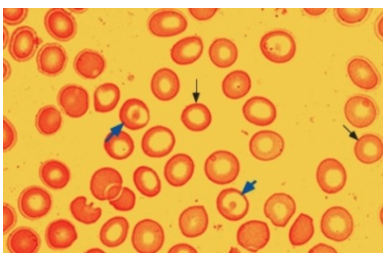

MCV가 80 fL보다 작을 때 microcytic이라고 합니다. Microcytosis는 보통 RBC 내의 헤모글로빈 양 감소와 동반하는데 이것은 hypochromic (low MCH)하게 만듭니다. Microcytosis를 일으키는 가장 흔한 원인 3가지는 ㈀ iron deficiency, ㈁ alpha 또는 beta thalassemia minor ㈂ anemia of inflammation (anemia of chronic disease, 덜 종종)이며 감별 진단을 위해서 다른 검사들이 필요합니다. ㈀ IDA를 구분짓는 가장 분별력 있는 특징들은 low serum ferritin concentration, increased total iron binding capacity (transferrin), low serum iron concentration이며 결과적으로 낮은 TSAT을 초래합니다. IDA 진단을 하게 되면 대장 출혈 (암과 같은), 과도한 생리출혈과 같은 IDA 원인을 찾아야 합니다. ㈁Thalassemia가 있는 성인은 대부분 종종 alpha 또는 beta forms의 heterozygotes여서 단지 빈혈이 거의 없을 수 있습니다. 그러므로 가족력도 종종 음성입니다. 신체진찰에서는 splenomagaly를 나타낼 수 있고 peripheral smear는 다양한 정도의 hypochromia, microcytosis, target cells, tear-drop forms, basophilic stippling 를 나타냅니다. RBC count는 실질적으로 증가할 수도 있고 uncomplicated patients는 정상 또는 증가된 iron stores를 갖습니다. ㈂ Anemia of inflammation의 핵심은 low serum iron, low total iron binding capacity (transferrin), normal to increased serum ferritin concentration입니다. 비록 hypochromic & microcytic red cells이 이 환자들에서 가장 빈번하게 보일지라도 low MCV는 hepatoma 또는 renal cell carcinoma 환자에서 가장 빈번하게 보입니다.
Beta thalassemia trait
Peripheral smear from a patient with beta thalassemia trait. The field shows numerous hypochromic and microcytic red cells (thin arrows), some of which are also target cells (blue arrows).
REF. UpToDate 2020.04.19
'혈액내과 > 조혈' 카테고리의 다른 글
| Pernicious anemia (PA)과 만성위축성위염 (자가면역관련 또는 만성헬리코박터감염) (0) | 2020.04.19 |
|---|---|
| Nondialysis CKD 환자에서 철분제 공급과 ESA 투약 시작 기준 (0) | 2020.04.19 |
| 철결핍성빈혈 가능성 (0) | 2020.04.19 |
| 빈혈 치료의 적응증, Indications for treatment (0) | 2019.08.06 |
| 만성질환 빈혈, Anemia of chronic disease(ACD) (0) | 2019.07.16 |